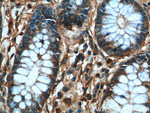
TBL2 Antibody in Immunohistochemistry (Paraffin) (IHC (P))

Search
Proteintech
TBL2 Monoclonal Antibody (1D5C2)
{{$productOrderCtrl.translations['antibody.pdp.commerceCard.promotion.promotions']}}
{{$productOrderCtrl.translations['antibody.pdp.commerceCard.promotion.viewpromo']}}
{{$productOrderCtrl.translations['antibody.pdp.commerceCard.promotion.promocode']}}: {{promo.promoCode}} {{promo.promoTitle}} {{promo.promoDescription}}. {{$productOrderCtrl.translations['antibody.pdp.commerceCard.promotion.learnmore']}}
产品信息
66307-1-IG
种属反应
宿主/亚型
分类
类型
克隆号
抗原
偶联物
形式
浓度
纯化类型
保存液
内含物
保存条件
运输条件
产品详细信息
Immunogen sequence: SNGKYLATC ADDRTIRIWS TKDFLQREHR SMRANVELDH ATLVRFSPDC RAFIVWLANG DTLRVFKMTK REDGGYTFTA TPEDFPKKHK APVIDIGIAN TGKFIMTASS DTTVLIWSLK GQVLSTINTN QMNNTHAAVS PCGRFVASCG FTPDVKVWEV CFGKKGEFQE VVRAFELKGH SAAVHSFAFS NDSRRMASVS KDGTWKLWDT DVEYKKKQDP YLLKTGRFEE AAGAAPCRLA LSPNAQVLAL ASGSSIHLYN TRRGEKEECF ERVHGECIAN LSFDITGRFL ASCGDRAVRL FHNTPGHRAM VEEMQGHLKR ASNESTRQRL QQQLTQAQVT LGGPGAED (100-446 aa encoded by BC012938)
靶标信息
This gene encodes a member of the beta-transducin protein family. Most proteins of the beta-transducin family are involved in regulatory functions. This protein is possibly involved in some intracellular signaling pathway. This gene is deleted in Williams-Beuren syndrome, a developmental disorder caused by deletion of multiple genes at 7q11.23.
仅用于科研。不用于诊断过程。未经明确授权不得转售。
篇参考文献 (0)
生物信息学
蛋白别名: DKFZP43N024; MGC134739; transducin -like 2; Transducin beta-like protein 2; Williams-Beuren syndrome chromosomal region 13 protein; Williams-Beuren syndrome chromosome region 13; WS beta-transducin repeats protein; WS-betaTRP
基因别名: TBL2; UNQ563/PRO1125; WBSCR13; WS-betaTRP
UniProt ID: (Human) Q9Y4P3
Entrez Gene ID: (Human) 26608